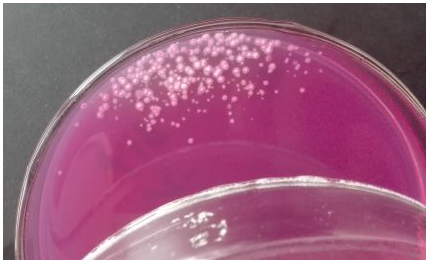

自霉菌和酵母菌計數正式開始實施以來,正置培養容易造成環境污染,一直比較困擾大家,很多小伙伴們反應國標霉菌正置培養容易污染,今天上海遠慕生物就來為大家分析一下這個問題。
GB 4789.15-2016相比GB 4789.15-2010,最大的區別可能就在于對平皿的培養方式。2016版的國標在5.2中要求:瓊脂凝固后,正置平板,置28℃±1℃培養箱中培養,觀察并記錄培養至第5d的結果。
其實針對這一條,需要注意兩點:
第一,是需要對平板進行觀察的,不能直接培養至第5天計數,因為霉菌的特殊性,在培養過程中會產生大量孢子,導致整個平板蔓延。因此,在培養后的第2天開始,就要對平板進行觀察,并計數典型菌落,而這樣的觀察在之后每一天都應該進行,直至培養第5天。
第二,就是正置培養。這一點是16版國標與舊版最大的區別,10版之前的國標都是倒置培養的。而進行正置培養,很多朋友可能都會遇到平板被霉菌污染的問題,比如圖中的情況,這怎么解決呢?
遇到這種情況,一開始我們也是十分疑惑,檢測方法的霉菌是從哪里來的呢!
其實造成這種情況的原因有很多種,可能有培養箱環境污染,平皿冷凝水污染,操作環境污染、培養基問題等等,這些問題都該如何解決呢?
污染原因與解決措施
一、培養箱環境污染
很多實驗室培養霉菌采用的是專用的霉菌培養箱,所以培養箱空間里會有大量的霉菌孢子。而平皿的蓋和底是有一定縫隙的,尤其是玻璃平皿縫隙還是比較大的,正置培養中,孢子會向上飛揚通過縫隙落到平板的培養基上,導致污染。細心地實驗猿可能發現,污染的菌落大部分都是在平皿邊緣生長的。用一次性塑料平皿來培養,污染的概率就會小很多,因為一次性塑料平皿的蓋和底之間的縫隙相比之下是比較小的。因此培養箱環境中的孢子可能會是主要污染源。
這樣一來,解決的方法就應該是對培養箱進行殺菌。可以考慮用紫外線殺一下菌,同時輔助消毒劑擦拭的方法,常用消毒劑比如75%酒精和新潔爾滅等,應該注意的是,這樣的殺菌操作也是需要經常進行的,因為霉菌的孢子是十分難清除的,而每次培養可能又會引進新的污染源,可以考慮每周進行兩次,保證培養環境無污染源。
二、平皿冷凝水污染
正置培養過程中,若是平皿的上蓋有泠凝水,在培養過程中冷凝水滴落到培養基上,也極容易造成菌落蔓延,平皿污染。因此在培養之前,一定要保證平皿干燥,可以把平皿放在37℃的環境里烘干,烘干之后再進行培養,就會避免這個原因造成的污染。
三、操作環境和培養基的污染
因為無菌室里可能也會因為滅菌效果不理想造成污染。小編之前工作的實驗室,操作臺使用紫外線滅菌,經常就會滅菌不徹底有孢子污染,尤其是在進行過霉菌的相關檢測之后。所以在進行過霉菌檢測之后,適當的增長滅菌時間,可能會達到比較理想的效果。另外,為了徹底解決無菌室空間孢子污染的問題,可以購買安裝臭氧發生器,通過紫外線+臭氧的雙重消毒模式,效果就十分理想了。
大家如果還是想驗證一下究竟是什么原因造成的污染,這里提供一個簡單的驗證試驗:在正常檢測的環境中倒一組空白平皿,將這些平皿分為AB兩組,其中A組用有充足氧氣的自封袋將平皿封好,B組不封,均放置在培養箱中正置培養。若是A組B組均有霉菌生長,則需要考慮培養基污染或者操作環境的污染;若是A組不生長霉菌而B組生長,則需要考慮是培養箱內的環境污染。通過這個小試驗,可以基本上確定污染源,然后針對污染源進行相應的處理。